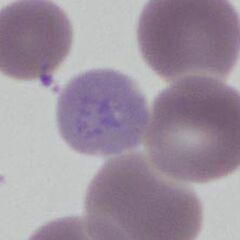

Cabot rings
From haematologyetc.co.uk
Described by: Richard Cabot (American physician in 1903)
Appearance
They are rarely seen; however when present their appearance is of violet coloured thin strands, that form single or double loops. Most often they are seen in polychromatic red cells.
Image: Cabot ring in 'figure of 8' appearance, within a pale (polychromatic) red cell
Significance
They reflect stressed or disordered haematopoiesis
Pitfalls
Occasionally water entering during slide-fixation can cause a ring-like appearance affecting multiple cells, this will generally affect large numbers of cells.
Causes
| OCCUR IN STATES OF STRESSED HAEMATOPOIESIS, examples below |
|---|
| Megaloblastic anaemias |
| Myelodysplasia and myelofibrosis |
| Drug effects. |
Pathobiology
These are residual microtubular structures that are believed to represent the remains of the mitotic spindle formed during cell division.